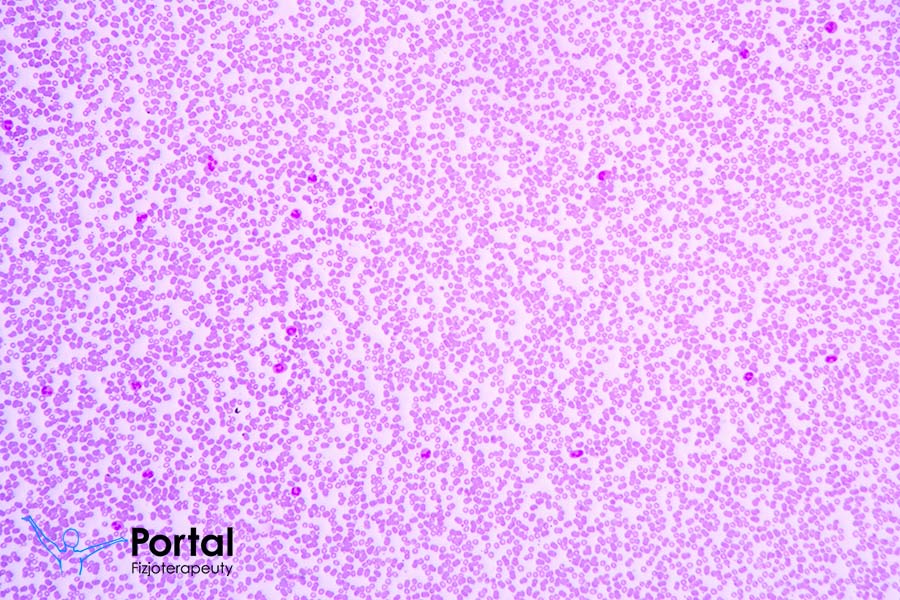
Morfologia krwi z rozmazem

Masaż relaksacyjny jest zdecydowanie najpopularniejszym i najbardziej lubianym zabiegiem wykonywanym na człowieku. Jest nie tylko przyjemny, ale także korzystnie oddziałuje na wiele układów organizmu.

Masaż relaksacyjny
Wymagający szef, natłok obowiązków, sprzątanie, gotowanie, nauka do sprawdzianów czy egzaminów. Hałas, ścisk, nieustający brak czasu. Dzieci, które potrzebują uwagi. Praca, w której wszystko musi być zrobione na już. Skądś to znasz?
Oczywiście. Każdy z nas przecież tego doświadczył, a nawet doświadcza codziennie. Życie prywatne i zawodowe. Duża ilość obowiązków. To wszystko powoduje stres, zmęczenie, chęć ucieczki. A gdybyś tak mogła choć na chwilę uciec od tego wszystkiego? Położyć się wygodnie, odprężyć i zrelaksować. Po prostu zamknąć oczy i nie myśleć o niczym lub tylko o czymś przyjemnym. Nie zawsze jest możliwe wyjechanie na urlop czy nawet jakiś krótszy wyjazd.
Co zrobić w takiej sytuacji, aby choć na chwilę zapomnieć o rachunkach do zapłacenia, sprawach do załatwienia i wielu, wielu innych rzeczach?
Zobacz również: rodzaje masażu – 10 najbardziej popularnych
Czym jest?
Rozwiązanie jest bardzo proste. Wystarczy skorzystać z masażu relaksacyjnego. Jest to jeden z przyjemniejszych rodzajów terapii manualnej. Ma on na celu zmniejszenie napięcia mięśni oraz napięcia psychicznego. Bardzo ważne jest jednak, aby taki masaż wykonywała wykwalifikowana osoba taka jak np. fizjoterapeuta, ponieważ nieprawidłowo wykonany może nie tylko nie spełnić oczekiwań, ale również może spowodować skutki uboczne.
Jednak właściwie przeprowadzony masaż relaksacyjny niesie ze sobą wiele korzyści. Ta metoda jest zalecana praktycznie dla wszystkich. Mogą być masowani zarówno kobiety, jak i mężczyźni. Młodzież i dorośli. Tego rodzaju masaż polecany jest szczególnie osobom mającym dużo obowiązków, żyjącym w stresie, a także uprawiającym sport. Warto więc z niego korzystać regularnie.
Zalety
Jest ich bardzo wiele. Działa on pozytywnie zarówno na aspekty zdrowotne organizmu, jak również poprawia samopoczucie. Ponadto pozwala choć na chwilę zapomnieć o problemach i obowiązkach. Do głównych zalet masażu relaksacyjnego zalicza się:
- zmniejszanie napięcia mięśni, co następnie przekłada się na rozluźnienie całego organizmu;
- odprężanie i głęboka relaksacja;
- zmniejszanie poziomu stresu, co powoduje poprawę wyglądu skóry jak również ujędrnia ciało;
- zmniejszanie zmęczenia fizycznego oraz psychicznego.
Ruchy ręki osoby wykonującej masaż pobudzają krążenie, co pozytywnie wpływa na układ nerwowy oraz ukrwienie ciała.
Przeciwwskazania
Przeciwwskazaniem do jego stosowania mogą być jedynie pewne schorzenia czy choroby, podczas których lekarz prowadzący nie zaleca stosowania masażu. Takich dolegliwości jest jednak mało, a w wielu przypadkach masaż jest wręcz zalecany.
Prawidłowo wykonany masaż relaksacyjny jest całkowicie bezpieczny. Zazwyczaj cechują go delikatne, rytmiczne ruchy rąk terapeuty. Czasem są używane aromatyczne olejki, nie posiadające drażniącego zapachu. Podczas takiego masażu często jest włączona relaksacyjna muzyka, która potęguję efekt wyciszenia i relaksu.
Kiedy najlepiej stosować i gdzie?
Z masażu relaksacyjnego można korzystać zazwyczaj przez cały rok. Staje się on także coraz bardziej popularny. W większych miastach (ale także coraz częściej w małych) jest on łatwo dostępny, a wybierać można spośród wielu ofert. Pojawiają się także oferty masażu w domu klienta (trzeba jednak pamiętać, aby wybrać osobę, która nie jest amatorem w tej dziedzinie).
Zaletą masażu jest też czas jego trwania – nie jest on za długi, dzięki czemu bez większych trudności można go dopisać do codziennego grafiku. Nie jest też za krótki, co pozwala na skorzystanie z jego licznych korzyści. Czas trwania umożliwia zrelaksowanie się i odprężenie po ciężkim dniu w pracy.
Masaż relaksacyjny w dużej mierze łagodzi skutki stresu, dlatego jego regularne stosowanie pomaga też w dolegliwościach związanych ze skutkami zmęczenia i ciągłego napięcia – taki masaż może pomóc w walce z bezsennością, nadpobudliwością, irytacją. Jest on doskonałym rozwiązaniem dla osób spędzających dużo czasu przed komputerem – rozluźnia mięśnie i dzięki temu ból pleców czy szyi znacząco się zmniejsza, a z czasem nawet ustępuje.
Dodatkowo prawidłowo wykonany masaż relaksacyjny pomaga również organizmowi w pozbyciu się toksyn, a wytworzone podczas masażu endorfiny pomogą w walce ze złym samopoczuciem.
Typy masażu relaksacyjnego
Wyróżnia się następujące typy masażu relaksacyjnego:
- gorącymi kamieniami;
- odchudzający;
- antycellulitowy;
- ujędrniający;
- aromaterapeutyczny;
- orientalny;
- stemplami;
- solą himalajską.
Masaż relaksacyjny wykonuje się przy zastosowaniu różnych technik. Głaskanie palcami lub całymi dłońmi ma poprawić krążenie krwi i limfy oraz złagodzić stres. To technika stosowana zazwyczaj na początku i na końcu zabiegu. Z kolei ugniatanie poprawia ukrwienie ciała. Rozcieranie poprzez uciskanie ciała dłońmi złożonymi w pięści (bez rozciągania skóry) korzystnie wpływa na likwidację cellulitu, złogów i obrzęków. Oklepywanie całą dłonią lub jej kantem pobudza krążenie. Powolne ruchy z wykorzystaniem środków ułatwiających poślizg, np. olejków aromatycznych, doskonale odpręża całe ciało.
Czas trwania pojedynczej sesji masażu relaksacyjnego wynosi około 1 godziny. To nie tylko zabieg odprężający, ale także upiększający ciało i korzystnie oddziałujący na zdrowie. Warto regularnie korzystać z tej prostej, ale niosącej pozytywne skutki, formy terapii manualnej.
Polecane produkty:

|
Kolagen w proszku na stawy, kości i skórę
Kolagen bioalgi zawiera aż 97% hydrolizowanego kolagenu. Jego opatentowana formuła sprawia, że wchłanialność jest na bardzo wysokim poziomie. Wspomaga łagodzenie objawów już istniejących chorób stawów, dodatkowo zapobiegając pojawianiu się nowych. Zobacz więcej... |

|
Kwas hialuronowy na stawy i skórę
Kwas hialuronowy zapewnia mazi stawowej właściwości lepko-sprężyste, przez co zmniejsza ból w stawach. Dodatkowo wypełnia przestrzenie w naskórku redukując zmarszczki. Sprawia, że skóra wygląda młodziej i polepsza się jej odcień, dając też efekt ... Zobacz więcej... |
Bibliografia
- Palejki K., Pogorzała A., Stryła W., Medyczne aspekty masażu relaksacyjnego na podstawie doświadczeń własnych, Innowacyjność i tradycja w fizjoterapii.
- Walaszek R., Masaż z elementami rehabilitacji, Wydawnictwo REHMED, Kraków 1998.